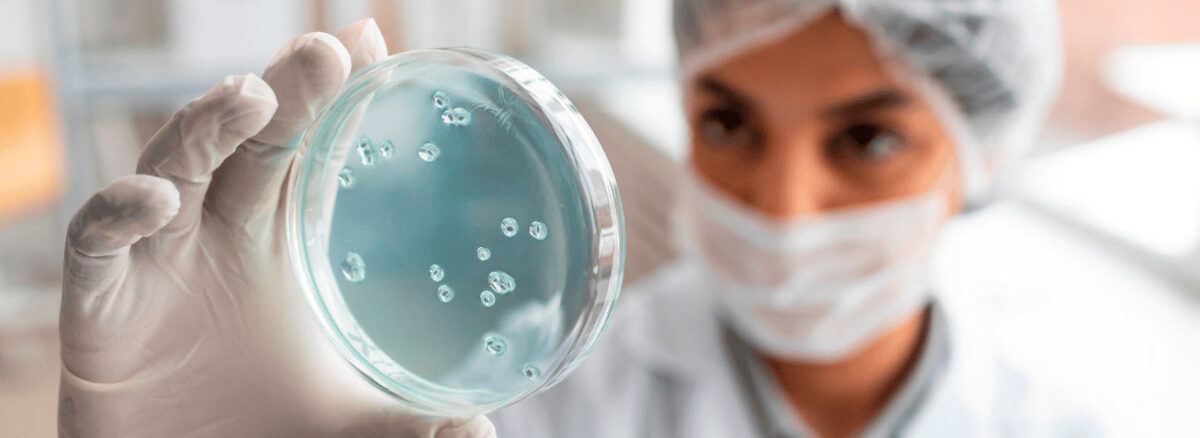
spx-clinica-spx-imagem-nova-terapia-celular-contra-o-cancer

- 10 de junho de 2025
- SPX Imagem
- Comment: 0
- News Médicos, Notícias, SPX, Explica
Nova Terapia Celular Contra o Câncer Ganha Força; Descubra!
Com a utilização de células CAR-T, entenda como essa terapia celular contra o câncer se mostra inovadora para o tratamento!
Recentemente, pesquisadores chineses divulgaram um avanço promissor no combate ao câncer. Um novo estudo mostrou que, a princípio, a terapia com células CAR-T aumentou em 40% a sobrevida de pacientes com câncer avançado na junção gástrica ou gastroesofágica (JGE), uma das formas mais agressivas da doença.
Os dados foram publicados no dia 2 de junho de 2025 na revista The Lancet e igualmente apresentados durante a Reunião Anual da Sociedade Americana de Oncologia Clínica (Asco), realizada em Chicago, nos Estados Unidos.
Este é o primeiro ensaio clínico controlado com CAR-T voltado para tumores sólidos — o que torna a descoberta ainda mais relevante.
Saiba Mais sobre a Nova Terapia Celular Contra o Câncer

Durante a fase 2 do ensaio clínico, os pesquisadores compararam o medicamento experimental satricabtagene autoleucel (satri-cel) com tratamentos convencionai em 156 pacientes. Logo, todos os participantes tinham câncer de estômago avançado, do tipo Claudin18.2-positivo, e já haviam tentado pelo menos duas terapias anteriores sem sucesso.
Contudo, entre os 88 pacientes que receberam o satri-cel, a maioria apresentou melhor controle da doença em comparação com os que seguiram tratamentos tradicionais. Além disso, esses pacientes viveram mais tempo sem progressão tumoral.
Dessa forma, a sobrevida sem avanço do câncer foi de 3,25 meses com satri-cel, contra 1,77 meses nos demais tratamentos. Segundo os pesquisadores, a diferença foi estatisticamente significativa e demonstra o potencial dessa nova abordagem.
“O satri-cel demonstrou eficácia inovadora com benefícios clínicos significativos e taxas de resposta tumoral muito melhores.”
– Lin Shen, professor do Hospital de Câncer de Pequim e principal pesquisador
Tratamento Inovador
No tratamento com CAR-T, os médicos modificam as células de defesa do próprio paciente para que reconheçam e combatam o tumor com mais eficiência. Nesse processo, os linfócitos T ganham uma espécie de “óculos especiais”, permitindo então que eles identifiquem com mais clareza as células cancerígenas e reajam de forma mais direta contra o inimigo.
No caso da nova terapia com satri-cel, o medicamento foi desenvolvido para atuar diretamente sobre a mutação Claudin18.2, bastante comum em tumores gástricos. Assim, o corpo passa a detectar esse alvo com mais facilidade.
Sob o mesmo ponto de vista, vale destacar que os pacientes do grupo experimental receberam até três infusões da terapia, com 250 milhões de células modificadas em cada aplicação — uma estratégia que intensifica a resposta imunológica contra o câncer.
Segurança e Potência no Combate ao Câncer
A maioria dos pacientes que receberam a terapia com satri-cel apresentaram eventos adversos de grau 3 ou superior. Dentre eles está a queda significativa nos níveis de linfócitos, leucócitos e neutrófilos. Contudo, esses efeitos apareceram igualmente nos pacientes submetidos ao tratamento tradicional.
Da mesma forma, alguns participantes do grupo controle, que não tiveram resposta ao tratamento inicial, foram beneficiados posteriormente com a infusão de satri-cel. Caracteriza-se, assim, uma medida que reforça a confiança dos especialistas no potencial terapêutico da abordagem.
Segundo Zonghai Li, diretor executivo da CARsgen Therapeutics, os resultados comprovam o avanço significativo dessa nova linha de tratamento. Ele enfatizou que o satri-cel pode representar uma opção promissora principalmente para tumores sólidos que deixam de responder às terapias convencionais.
Foto: Montagem-Instagram/Paulocfperegrino

Novas Esperanças para Cânceres Sólidos
Atualmente, a terapia com células CAR-T trata tipos específicos de leucemia e linfoma. Ainda assim, pesquisadores já ampliam os estudos para incluir cânceres sólidos, que tradicionalmente apresentam maior dificuldade para resposta a essa tecnologia.
O tratamento com CAR-T, ademais, é aplicado principalmente em pacientes que já passaram por várias tentativas de tratamento antes de serem incluídos nos ensaios clínicos. Como resultado, a expectativa é que, no futuro, essa terapia seja oferecida em estágios mais precoces, buscando aumentar a sobrevida dos pacientes.
Referência: Portal Metrópoles.
Participe do Canal do WhatsApp da SPX!
Gostou? Clique aqui e acompanhe outros conteúdos da SPX Clínica. Dicas de saúde, novidades e muito mais. Fique por dentro do mundo da saúde!
Últimas Notícias

Dispositivo pode Identificar Doenças Através das Fezes; Veja!
Descubra como um novo dispositivo inteligente pode identificar doenças através das fezes, por meio de sensores e algoritmos!

Progresso de Vacinas contra o Câncer: O Que Esperar?
Conheça o progresso de vacinas contra o câncer mais promissores, as imunizações em teste e o que a ciência projeta para o futuro!

Pesquisa Brasileira: Avanço contra Tipos Raros de Câncer Infantil
Novo estudo abre leque para criação de terapias personalizadas em relação a alguns tipos raros de câncer infantil. Saiba mais!

Novas Técnicas para Desengasgo: Veja o Guia Completo!
Confira quais as novas técnicas para desengasgo de acordo com as autoridades, válidas para bebês, crianças e adultos

Inédito: Nanopartículas Ajudam a Reverter Alzheimer
Com o trabalho de cientistas de diferentes países, descobriu-se que nanopartículas ajudam a reverter alzheimer após teste em camundongos

Resistência ao Tratamento do Câncer de Mama: Veja os Motivos!
Devido a variações de uma proteína, um estudo buscou entender por que alguns pacientes apresentam resistência ao tratamento do câncer de mama